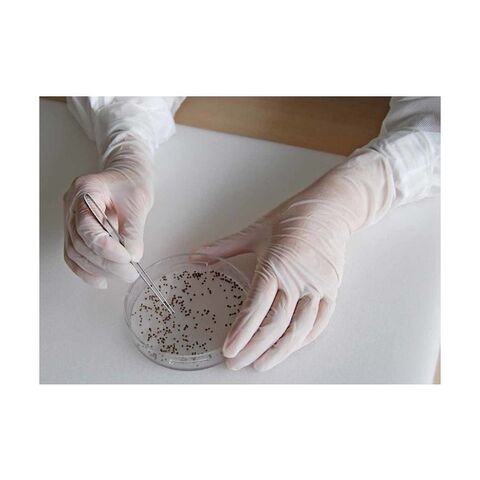

2/6
時点_ポイント最大11倍
シンコー ショーワB0120ニトリルスタット100枚入パウダーフリーMサイズ 353 x 302 x 68 mm B0120M
販売価格
3,705
円 (税込)
- 出荷目安:
- 本日出荷(15時まで/土日祝除/代引NG)
たまるdポイント(通常) 33
+キャンペーンポイント(期間・用途限定) 最大10倍
※たまるdポイントはポイント支払を除く商品代金(税抜)の1%です。
※表示倍率は各キャンペーンの適用条件を全て満たした場合の最大倍率です。
各キャンペーンの適用状況によっては、ポイントの進呈数・付与倍率が最大倍率より少なくなる場合がございます。
dカードでお支払ならポイント3倍
各キャンペーンの適用状況によっては、ポイントの進呈数・付与倍率が最大倍率より少なくなる場合がございます。
- 商品情報
- レビュー
[###商品名]
●イオンコンタミネーションが少なく、手袋から不純物が発生しにくいタイプです。
●ぬぎはめしやすくするため、手袋内面に特殊処理を施しています。
●帯電防止効果があります。
●全長29cmのニトリルゴム製使いきり手袋です。
●電気電子部品製造業。
●機械工業。
●食品加工業。
●自動車関連業。
●クリーンパックではありません。
[###商品名]の特徴
●色:ホワイト
●サイズ:M
●全長(cm):29
●手のひら周り(cm):19.6
●中指長さ(cm):7.6
●表面抵抗値:1×10[[の10乗]]Ω
●厚み:約0.1mm
●左右兼用
●粉なし
[###商品名]の仕様
| 材質 | ●ニトリルゴム |
| 原産国 | マレーシア |